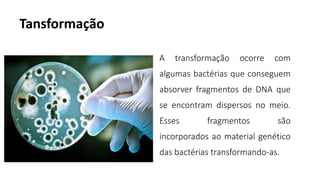
Tansformação
A transformação ocorre com
algumas bactérias que conseguem
absorver fragmentos de DNA que
se encontram dispersos no meio.
Esses fragmentos são
incorporados ao material genético
das bactérias transformando-as.

O documento descreve as características do Reino Monera, que inclui bactérias e cianobactérias. São organismos unicelulares procariontes que podem ser autótrofos ou heterótrofos. O documento também fornece detalhes sobre a estrutura, reprodução e importância das bactérias e cianobactérias.